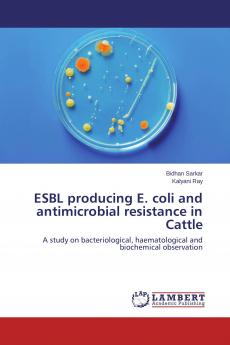
ESBL producing E. coli and antimicrobial resistance in Cattle
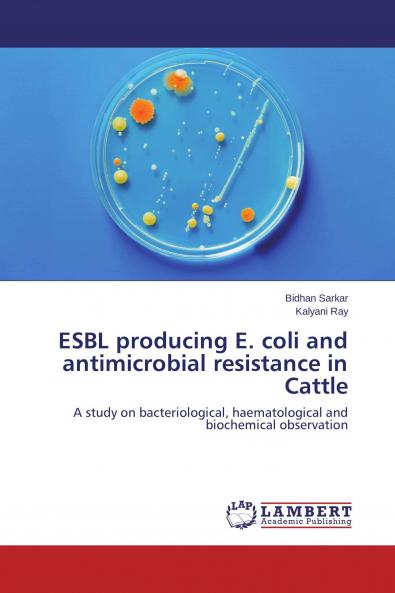
ESBL producing E. coli and antimicrobial resistance in Cattle
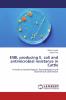
ESBL producing E. coli and antimicrobial resistance in Cattle

English
Paperback
₹4195
(All inclusive*)
Delivery Options
Please enter pincode to check delivery time.
*COD & Shipping Charges may apply on certain items.
Review final details at checkout.
Looking to place a bulk order? SUBMIT DETAILS
Delivery Options
Please enter pincode to check delivery time.
*COD & Shipping Charges may apply on certain items.
Review final details at checkout.
About The Book
Description
Author
E. coli are commonly found in the intestinal tract of humans and other animal species and constitute a reservoir of resistant genes for potentially pathogenic bacteria. E. coli are one of the important bacterial pathogens responsible for uterine infections in cow. Extended-spectrum beta-lactamases (ESBLs) are a novel group of enzyme was detected in the mid-1980s among Serratiamarcescens and Klebsiellapneumoniae in Germany which produced by bacteria belongs to Enterobacteriaceae family and confer resistance to an extended-spectrum of cephalosporins besides penicillins and monobactams. From the study it was observed that on average crossbred are most susceptible to reproductive diseases than the local cows and E. coli is one of the etiological factors of uterine infections in cow.A total of 63 E. coli isolates 45 (71.42%) 43 (68.25%) 44 (69.84%) 40 (63.43%) and 35 (55.55%) isolates were resistant against cefpodoxime aztreonum ceftazidime cefepime and ceftriaxone respectively. Furthermore resistance was also observed totetracycline ampicillin gentamicin norfloxacin clotrimoxazole and chloramphenicol were 100% 100% 84.12% 95.23%77.77% and 25.39% respectively.
Details
ISBN 13
9783659795046
Publication Date
-04-11-2015
Pages
-68
Weight
-106 grams
Dimensions
-150x220x4.09 mm